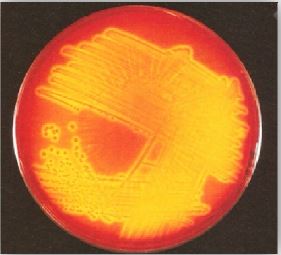

النبات

مواضيع عامة في علم النبات

الجذور - السيقان - الأوراق

النباتات الوعائية واللاوعائية

البذور (مغطاة البذور - عاريات البذور)

الطحالب

النباتات الطبية


الحيوان

مواضيع عامة في علم الحيوان

علم التشريح

التنوع الإحيائي

البايلوجيا الخلوية


الأحياء المجهرية

البكتيريا

الفطريات

الطفيليات

الفايروسات


علم الأمراض

الاورام

الامراض الوراثية

الامراض المناعية

الامراض المدارية

اضطرابات الدورة الدموية

مواضيع عامة في علم الامراض

الحشرات


التقانة الإحيائية

مواضيع عامة في التقانة الإحيائية


التقنية الحيوية المكروبية

التقنية الحيوية والميكروبات

الفعاليات الحيوية

وراثة الاحياء المجهرية

تصنيف الاحياء المجهرية

الاحياء المجهرية في الطبيعة

أيض الاجهاد

التقنية الحيوية والبيئة

التقنية الحيوية والطب

التقنية الحيوية والزراعة

التقنية الحيوية والصناعة

التقنية الحيوية والطاقة

البحار والطحالب الصغيرة

عزل البروتين

هندسة الجينات


التقنية الحياتية النانوية

مفاهيم التقنية الحيوية النانوية

التراكيب النانوية والمجاهر المستخدمة في رؤيتها

تصنيع وتخليق المواد النانوية

تطبيقات التقنية النانوية والحيوية النانوية

الرقائق والمتحسسات الحيوية

المصفوفات المجهرية وحاسوب الدنا

اللقاحات

البيئة والتلوث


علم الأجنة

اعضاء التكاثر وتشكل الاعراس

الاخصاب

التشطر

العصيبة وتشكل الجسيدات

تشكل اللواحق الجنينية

تكون المعيدة وظهور الطبقات الجنينية

مقدمة لعلم الاجنة


الأحياء الجزيئي

مواضيع عامة في الاحياء الجزيئي


علم وظائف الأعضاء


الغدد

مواضيع عامة في الغدد

الغدد الصم و هرموناتها

الجسم تحت السريري

الغدة النخامية

الغدة الكظرية

الغدة التناسلية

الغدة الدرقية والجار الدرقية

الغدة البنكرياسية

الغدة الصنوبرية

مواضيع عامة في علم وظائف الاعضاء

الخلية الحيوانية

الجهاز العصبي

أعضاء الحس

الجهاز العضلي

السوائل الجسمية

الجهاز الدوري والليمف

الجهاز التنفسي

الجهاز الهضمي

الجهاز البولي


المضادات الميكروبية

مواضيع عامة في المضادات الميكروبية

مضادات البكتيريا

مضادات الفطريات

مضادات الطفيليات

مضادات الفايروسات

علم الخلية

الوراثة

الأحياء العامة

المناعة

التحليلات المرضية

الكيمياء الحيوية

مواضيع متنوعة أخرى

الانزيمات
الحالات المرضية البكتيرية : الحالة الحادية عشر
المؤلف:
عبد الرزاق سليمان التومي ، محمد محمد الامام ، عبد الباسط رمضان
المصدر:
اساسيات التشخيص البكتريولوجي المعملي والسريري
الجزء والصفحة:
30-8-2016
1737
الحالات المرضية البكتيرية : الحالة الحادية عشر
امرأة تعاني من تمزق متكرر للأغشية وذلك خلال الاسابيع 40/32 من الحمل. بدأ المولود بعد 24 ساعة من ولادته يعاني من ارتفاع في درجة الحرارة كما بدأ يتوجع . اخذت منه عينة دم لزراعتها كما في الشكل رقم 1 والتي أظهرت نمواً جرثومياً بعد 24 ساعة وصبغت هذه الجراثيم المعزولة بتقنية صبغة جرام فكانت نفس الكائن الدقيق الذي تم عزله من سائل النخاع الشوكي (CSF) الشكل رقم 2.
الشكل رقم 1 المزرعة البكتيرية

الشكل رقم 2 الفحص المجهري
الأسئلة :
1- ما تعريفك للكائن الدقيق المسبب لهذا المرض ؟ وما هي الكائنات الدقيقة الاخرى التي بإمكانها إحداث مرض التهاب السحايا في مثل هذه المجموعة العمرية ؟
2- كيف يتم تصنيف هذا الكائن الدقيق ؟ وما الأهمية السريرية لهذا التصنيف؟
3- ما هي العوامل التي تساعد هذا الكائن الدقيق على إحداث المرض؟
4- كيف ستتم معالجة هذه الحالة؟
الإجابة :
1- في الأغلب فإن الكائن الدقيق المسبب لهذا المرض هو النوع البكتيري Streptococcus agalactiae وهو النوع المحلل تحليلاً كلياً لكريات الدم الحمراء عند زراعة هذه البكتيريا في الوسط الغذائي Blood agar ويسمى هذا النوع من التحلل B-haemolysis هي من المجموعة B لتصنيف Lancefield . الشريحة المصبوغة جرام توضح أن الكائن الدقيق المعزول عبارة عن كريات موجبة لهذه الصبغة ويعتبر هذا النوع من البكتيريا المسبب الرئيسي لمرض التهاب السحايا في مثل هذه المجموعة العمرية ، وغالباً ما تكون الإصابة في الأيام الاولى من الولادة حيث تحدث إصابة لكامل اجهزة المولود بما في ذلك الجهاز التنفسي دون أن تكون هناك علامات منذرة بحدوث مرض التهاب السحايا. وقد تصيب هذه البكتيريا الأطفال الرضع البالغين من العمر عدة أيام ، وتظهر الأعراض السريرية بوضوح عند عمر 10 أيام.
2- هناك سبعة أنواع من هذه البكتيريا المكونة للحافظة ويعتمد التقسيم على النوع المصلي وذلك من خلال المواد الكربوهيدراتية المكونة للجدار الخلوي وهذه الانواع كالتالي : Ia ، Ib ، II ، III ، IV ، V و VI . من هنا فإن وجود ما يعرف بتجرثم الدم خلال اليوم الأول والثاني من الولادة يكون في الغالب نتيجة الاصابة بالنوع Ib Ia ، أو النوع II . أما النوع III فهو المسؤول عن 80% من حالات الإصابة بالتهاب السحايا . إن الاصابة بهذا المرض في الأيام الاولى من العمر يكون نتيجة انتقال البكتيريا المسببة للمرض من الأم، اما الإصابة في الأيام التالية للولادة فيكون ذلك نتيجة تلوث البيئة المحيطة بالمولود أو انتقال العدوى من مولود آخر مصاب.
3- العوامل التي تساعد على حدوث هذه الإصابة في الأيام الاولى من العمر غالباً ما تكون نتيجة إصابة الأم الحامل بهذه البكتيريا (وهي تشكل حوالي 25%) وتختلف هذه النسبة بناءاً على طول فترة الحمل وتعتمد احتمالية إصابة المولود حديث الولادة بهذه البكتيريا على كمية المستعمرات البكتيرية التي تحملها الأم الحامل أثناء الولادة ، كما أن نسبة حدوث مرض التهاب السحايا تزداد في الأطفال الخدج ومواليد الأمهات اللاتي يعانين من تمزق متكرر للأغشية أو اللاتي يشتكين من التهاب السلي amnionitis.
4- يتم العلاج باستعمال المضاد الحيوي Penicillin والمضاد الحيوي Gentamicin.
هناك اقتراحان لتجنب حدوث هذا المرض في الأيام الاولى للولادة بهذا النوع من البكتيريا وذلك إما باستعمال المضاداتا الحيوية الواقية من هذا المرض أو التحصين بالتقليح . في الدول التي ينتشر فيها إصابة المواليد بهذه النوع البكتيري النوع b مثل الولايات المتحدة الأمريكية يتم إجراء مسح دوري للمواليد مع إعطاء المضاد الحيوي ampicillin للأمهات المعروف مسبقاً أنهن يحملن هذا النوع من البكتيريا وذلك أثناء الولادة . حالياً هناك طعم يستعمل للتحضين من هذا النوع من البكتيريا وقد أعطى نتائج جيدة.
الاكثر قراءة في البكتيريا
اخر الاخبار
اخبار العتبة العباسية المقدسة
الآخبار الصحية

قسم الشؤون الفكرية يصدر كتاباً يوثق تاريخ السدانة في العتبة العباسية المقدسة
"المهمة".. إصدار قصصي يوثّق القصص الفائزة في مسابقة فتوى الدفاع المقدسة للقصة القصيرة
(نوافذ).. إصدار أدبي يوثق القصص الفائزة في مسابقة الإمام العسكري (عليه السلام)